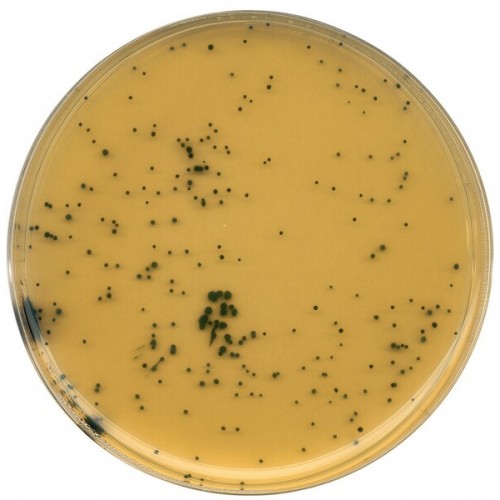

TSC AGAR (TRYPTONE SULFITE CYCLOSERINE AGAR) BASE MERCK - 500g
Modelo: 1119720500
-
R$800,25
ou até 3x de R$266,75 sem juros
Economize 5% no PIX: R$760,24
ou 3.5% no boleto: R$772,24
Consulte aqui o valor do frete e prazo de entrega
Descrição
Composição: (g/litre)
Tryptose 15.0;
Peptone from soymeal 5.0;
Yeast extract 5.0;
Sodium disulfite 1.0;
Ammonium iron(III) citrate 1.0;
Agar-agar 15.0.
A ser adicionado:
Cycloserine 0.4 or polymyxin 0.003;
Kanamycin 0.012.
Preparação:
Suspender 42 g/litro, dispensar em frascos adequados, autoclavar (15 min a 121 °C). Adicionar a substância necessária, mistura, pour plates.
SFP AGAR: Antes da autoclavação, adicionar 3mg de sulfato de POLIMIXINA por litro e 12mg de dissulfato de KANAMICINA por litro de meio de cultura base. Estes antibióticos podem ser adicionados ao meio de cultura estéril e liquefeitona forma de soluções filtradas e esterilizadas.
TSC AGAR: Esfrie o meio de cultura liquefeito a aproximadamente 50 °C, adicione 0.4 g de CICLOSERINE por litro (10 ml de solução 5% filtrada e esterilizada). Alternativamente, você pode usar o Suplemento Clostridium Perfringens Merck Cat. No. 1008880010
Considerando que o meio de cultura base preparado pode ser estocado por alguns meses, o meio de cultura seletivo pronto-uso deve ser usado em 4 dias após a preparação.
pH:7.6 ± 0.2 at 25 °C.
Tryptose 15.0;
Peptone from soymeal 5.0;
Yeast extract 5.0;
Sodium disulfite 1.0;
Ammonium iron(III) citrate 1.0;
Agar-agar 15.0.
A ser adicionado:
Cycloserine 0.4 or polymyxin 0.003;
Kanamycin 0.012.
Preparação:
Suspender 42 g/litro, dispensar em frascos adequados, autoclavar (15 min a 121 °C). Adicionar a substância necessária, mistura, pour plates.
SFP AGAR: Antes da autoclavação, adicionar 3mg de sulfato de POLIMIXINA por litro e 12mg de dissulfato de KANAMICINA por litro de meio de cultura base. Estes antibióticos podem ser adicionados ao meio de cultura estéril e liquefeitona forma de soluções filtradas e esterilizadas.
TSC AGAR: Esfrie o meio de cultura liquefeito a aproximadamente 50 °C, adicione 0.4 g de CICLOSERINE por litro (10 ml de solução 5% filtrada e esterilizada). Alternativamente, você pode usar o Suplemento Clostridium Perfringens Merck Cat. No. 1008880010
Considerando que o meio de cultura base preparado pode ser estocado por alguns meses, o meio de cultura seletivo pronto-uso deve ser usado em 4 dias após a preparação.
pH:7.6 ± 0.2 at 25 °C.
Etiquetas: TSC, agar, TSC agar base